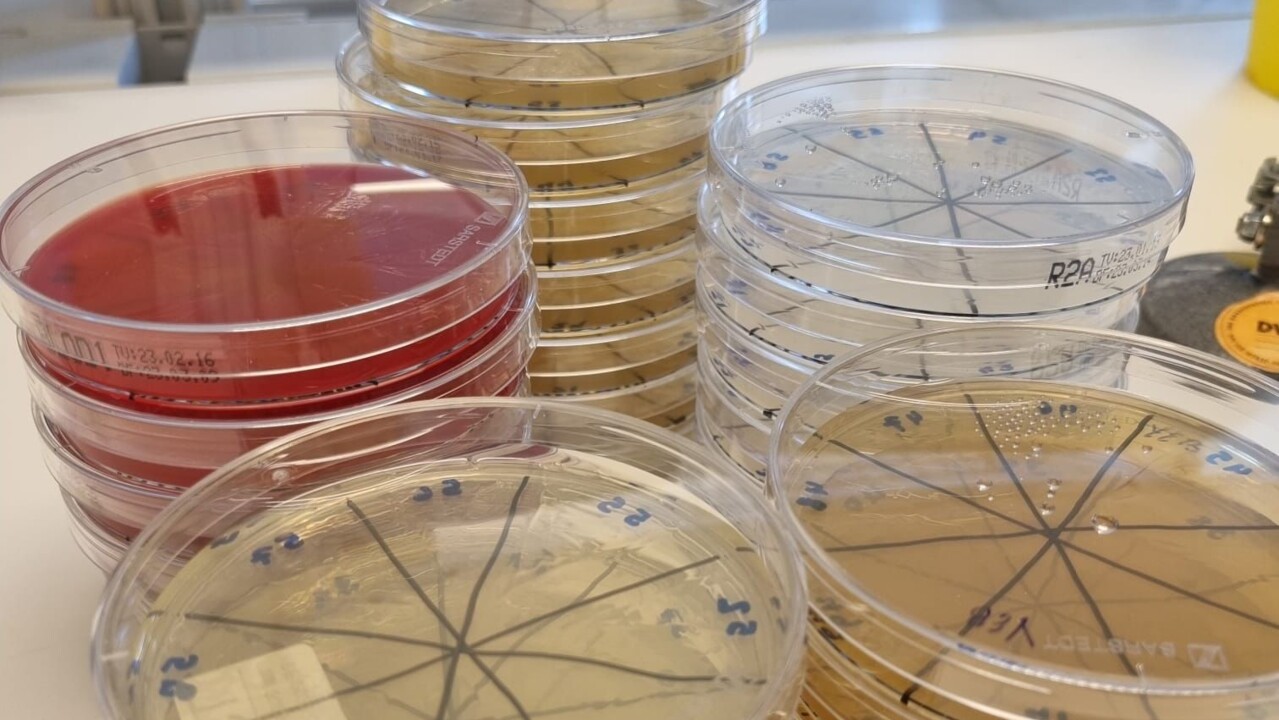
bakterier, växtvägg

Unveiling of the plant wall / Växtvägg
The plant wall will be unveiled at the end of UID23 | Design Talks & Degree Show
Time: 12.15-12.45 on 31 May.
Venue: Umeå University Arts Campus, river level, between the atrium and the UID workshops
Right now you are surfing a limited version of umu.se. What does this mean?
NEWS Pioneered by students, a new initiative has been launched – the vast, withering plant wall at the heart of the Arts Campus is about to be reborn. It is presenting an opportunity for students in design, forestry, and molecular biology to explore the interactive elements of the plant wall as well as seedling cultivation and the influence of bacteria on plant indoor survival.

The new plant wall will be unveiled at the end of UID23 | Design Talks & Degree Show 31 May.
ImageUID“With the return of the wall we want to create opportunities for interactions between people and the plant wall, as well as between the people that will engage in this space. We have spent the last couple of months trying to make it more tangible”, says William Roskaer, student in the Bachelor Programme in Industrial Design and part of the Climate Group at Umeå Institute of Design.
Once a vibrant façade welcoming people entering from the walkway by the Ume River, the formerly lush exterior of the UID workshops has recently acted a glum reminder of a distant spring. But where others saw decay, students in the Umeå Institute of Design Climate Group spotted an opportunity in the perishing plant wall.
Together with partners from SLU Forest Sciences, the Department of Molecular Biology, Umeå Centre for Microbial Research (UCMR), and Vertisà AB they are now bringing a unique climate ecosystem inside to inspire education, sensory engagement, and research.
Quite miraculously, there are a few plants that have been able to stay alive in the former plant wall without water, for months. What made these plants survive?

Undergraduate thesis students, Hanna Forsberg and Rana Zeeb, from the Department of Molecular Biology at Umeå University.
ImageDepartment of molecular biologyUndergraduate thesis students, Hanna Forsberg and Rana Zeeb, from the Department of Molecular Biology at Umeå University, were intrigued that there were some surviving plants, and since they knew that they were not taken care of at all, their attention was turned to the soil since it is a factor that has never changed since the plants were installed. Similarly, they were curious about the air condition in the presence of such plants.
“It got us wondering whether there were some bacteria that could be only found in surviving plants and other bacteria that could only found in dead plants. From this, we reasoned that if we find such bacteria then we could hypothesise that those bacteria promote plant survival. Also, the other harmful bacteria that are only found in dead plants suggest some environmental health conditions for plants to avoid the presence of such bacteria. This was the starting point of our thesis work,” says Rana Zeeb.
“Since we focused mainly on soil and air, we did not analyse the actual plants even though samples were collected. Focusing on plants will be another major point that would need its own analysis and hypothesis. That, we did not have time to do,” says Hanna Forsberg.
The students have spent many hours by the microscope, finally managing to identify all the bacteria they found on the wall.
ImageDepartment of molecular biologyThe few surviving plants have been integrated into the new wall as a testament to nature’s innate resilience.
Part of the mission is to find out which plants growing in the Swedish nature that can survive and thrive in an indoor climate. But the final wall concept will not only focus on the West Bothnian vegetation found in our local forests. Exotic plants, along with edible herbs and vegetables, will also be part of the eclectic mix of greeneries.

William Roskaer, UID student and part of the Climate Group.
ImageUID"In the end, we arrived at a couple different systems that we implement. On the left side, we will showcase a variety of plants from all over the world. From there, we move towards the plants that were rescued from the old wall. The main section will then showcase the Swedish boreal forest wrapped in an artistic panel made from living mycelium, the fungus that produces mushrooms”, says William Roskaer.
Besides from growing the connection between people and the surrounding nature, there is a clear mission with the wall to facilitate a stronger communal experience in the amazing joint space of Arts Campus, connecting Umeå Institute of Design, Umeå School of Architecture, Umeå Academy of Fine Arts and the internationally renowned arts venue Bildmuseet.
The unveiling of the plant wall takes place at The Institute of Design at Arts Campus on 31 May at 12:15.
Växtvägg is a growing collaboration between Umeå Institute of Design and the UID student-led Climate Group, the Department of Molecular Biology and Umeå Centre for Microbial Research (UCMR) at Umeå University, SLU Faculty of Forest Sciences and Vertisà AB.

In the future, one possibility is to undertake a microenvironmental analysis using artificial intelligence for identification of the sampled bacterial colonies.
ImageDepartment of molecular biologyThe plant wall will be unveiled at the end of UID23 | Design Talks & Degree Show
Time: 12.15-12.45 on 31 May.
Venue: Umeå University Arts Campus, river level, between the atrium and the UID workshops